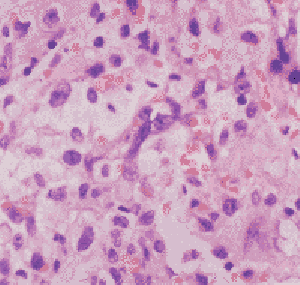
肝血管肉瘤

肝血管肉瘤
肝血管肉瘤疾病描述
肝血管肉瘤又稱血管內皮細胞肉瘤或惡性血管內皮瘤,是由肝竇細胞異形增生所形成的原發性惡性腫瘤。它是血管源性惡性腫瘤中最常見的一種,但與其他肝臟腫瘤相比,仍然是少見的。而在國外肝血管肉瘤為最常見的原發性肝臟肉瘤。日本曾報導17417 例原發性肝臟惡性腫瘤屍檢中有40 例為肝血管肉瘤。美國年發生約25 例。在我國僅偶有發現。
症狀體徵
為不明原因的肝大,伴有一些消化道症狀,可有腹痛、腹部不適、乏力、噁心、食慾差、體重減輕、發熱等。病程進展較快,晚期可有黃疸、腹水,腹水呈淡血性。常有肝外轉移,多為血行播散,可轉移至肺、胰、脾、腎和腎上腺等,以肺轉移最為常見。
疾病病因
絕大多數肝血管肉瘤病因不明。Folk 等調查168 例,其中75%的病例原因不明。近年來國外報導一些與化學物質有關的肝血管肉瘤,因此受到人們的關注,認為與接觸氯乙烯有關,美國一個氯乙烯廠1183 名工人中有7 例發生肝血管肉瘤,平均潛伏期為17 年。少數還可發生於服用合成類固醇、雌激素及避孕藥後,其潛伏期在10 年以上。
病理生理
 肝細胞
肝細胞1.大體檢查 腫瘤多為單個圓形灶,邊界較清,可有纖維包膜。切面為灰白或棕黃凍膠狀發亮組織,與出血、壞死灶交錯排列,瘤體內可見充滿不凝血液的大腔隙。在同膠質二氧化釷或氯化烯接觸的病例還常見有網質狀纖維化,脾臟也常腫大。
2.病理組織學檢查 腫瘤由紡錘狀或不規則形狀的惡性內皮細胞構成,其邊界不清。細胞質嗜酸性、核深染,形態狹長或不規則,胞核核仁可大可小,同樣嗜酸性。亦可見大而異形的細胞核以及多核細胞,核分裂象常見。薄壁靜脈散布於腫瘤內,約半數病例見有造血細胞灶。免疫組織學檢查可見瘤細胞中存在有Ⅷ因子相關抗原。腫瘤細胞沿著原有血管腔增殖,肝終端小靜脈和門靜脈分支亦顯示增殖。腫瘤細胞在肝血竇內增殖可導致進行的肝細胞萎縮,肝板斷裂,血管腔增大形成大小不一的空腔。腔壁粗糙不平,內壁襯以腫瘤組織細胞,有時為息肉樣或乳頭狀突出物,腔內充滿凝血塊和腫瘤細片。腫瘤侵及肝終端小靜脈和門靜脈分支可導致這些血管的堵塞,此可解釋為何腫瘤常易發生出血、梗死和壞死。有時腫瘤細胞密聚成小結節狀實性團塊,類似纖維肉瘤。
發病原因
(一)發病原因
肝血管肉瘤是一種間質性腫瘤惡性程度很高多數患者病因不明Folk等調查168例其中75%的病例原因不明近年來國外報導一些與化學物質有關的肝血管肉瘤因此受到人們的關注,認為與接觸氯乙烯有關美國一個氯乙烯廠1183名工人中有7例發生肝血管肉瘤平均潛伏期為17年少數還可發生於服用合成類固醇雌激素及避孕藥後其潛伏期在10年以上
氯乙烯是聚乙烯製造過程產生的氣體氯乙烯受內質網酶的作用轉化為致突變和致癌的代謝產物然後再與DNA共價結合實驗表明讓大鼠或人長期接觸氯乙烯能誘發肝血管肉瘤飲水含無機砷葡萄園內使用無機砷及硫酸銅等殺蟲劑長期接觸可發生肝血管肉瘤廣島核子彈爆炸及鐳錠外照射治療乳癌分別在36年及3年後各發生血管肉瘤1例該病也見於長期套用亞砷酸鉀治療牛皮癬的患者引起肝血管肉瘤的其他物質有鐳無機銅和單胺氧化酶抑制劑亦有特發性血色病發生血管肉瘤的報導人類肝血管肉瘤發病有關的因素(表1)
(二)發病機制
肝血管肉瘤的演變過程可能有下列5個主要途徑:①肝小葉竇內皮細胞從非典型增生到間變細胞增生;②肝細胞初期增生隨之萎縮和消失;③竇周間隙纖維組織增生;④進行性竇擴張到血腫形成;⑤竇壁細胞和匯管區毛細血管內皮細轉化為肉瘤細胞
1.大體檢查
血管肉瘤往往呈多中心性發生多累及兩個肝葉其肉眼觀特徵是許多充滿血液的囊直徑可達1~15cm5cm者多見腫瘤多為單個圓形實體瘤生長大小不等表面呈多結節狀界限清楚但無包膜較大的腫塊呈海綿狀最大的重達3kg可伴有血栓形成和繼發壞死切面為灰白或棕黃膠凍狀發亮組織與出血壞死灶交錯排列瘤體內可見充滿不凝血液的大腔隙在接觸膠質二氧化釷或氯乙烯的病例中還常見有網織狀纖維化脾臟腫大但合併肝硬化者少見
2.病理組織學檢查
腫瘤由紡錘狀或不規則形狀的惡性內皮細胞構成其邊界不清細胞質嗜酸性核深染形態狹長或不規則胞核核仁可大可小同樣嗜酸性亦可見大而異形的細胞核以及多核細胞核分裂象常見薄壁靜脈散布於腫瘤內約半數病例見有造血細胞灶免疫組織學檢查可見瘤細胞中存在有Ⅷ因子相關抗原腫瘤細胞沿著原有血管腔增殖肝終端小靜脈和門靜脈分支亦顯示增殖腫瘤細胞在肝血竇內增殖可導致進行的肝細胞萎縮肝板斷裂血管腔增大形成大小不一的空腔腔壁粗糙不平內壁襯以腫瘤組織細胞有時為息肉樣或乳頭狀突出物腔內充滿凝血塊和腫瘤細
片腫瘤侵及肝終端小靜脈和門靜脈分支可導致這些血管的堵塞此可解釋為何腫瘤常易發生出血梗死和壞死有時腫瘤細胞密聚成小結節狀實性團塊類似纖維肉瘤
套用免疫組織化學技術可發現腫瘤細胞中Ⅷ因子相關抗原呈陽性
在大多數病例中腫瘤可侵犯門靜脈或中央靜脈這種情況多發生於腫瘤結節內但亦可發生在遠處的肝小葉骨髓外造血灶常見可因微血管溶血性貧血而繼發鐵質沉著在膠質二氧化釷誘發的肝血管肉瘤中容易見到膠質二氧化釷沉積於網狀內皮細胞內或游離於匯管區Glisson鞘膜或肝終端小靜脈壁內該沉積物無色可折光HE染色沉積物通常呈粉紅和棕黃色放射自顯影可顯示二氧化釷發出的α射線表現為短的點狀軌跡能量分散X射線微量分析亦可測出釷元素由二氧化釷砷或氯乙烯引起的血管肉瘤在非腫瘤組織中往往有肝硬化和纖維化約1/3患者有特發性肝硬化由明確致病因子引起的腫瘤與特發性腫瘤之間無形態學上的差別
診斷檢查
 白細胞
白細胞實驗室檢查:包括貧血、白細胞增多(65%)或白細胞減少(25%),血小板減少(62%)。約2/3 的病人有肝功能異常。一組病例磺溴酞鈉瀦留試驗(BSP)陽性者占100%,ALP 升高占85%,凝血酶原時間延長占72%,高膽紅素血症60%,部分病人有ALT升高。
其他輔助檢查:胸部X線片可示有肺不張或胸膜腫塊,在同膠質二氧化釷有關的血管肉瘤病例中,腹部平片能發現不透明的肝、脾和腹腔淋巴結影。CT 可發現不勻質低密度占位病變及腫瘤破裂影像。肝血管造影顯示異常血管形態,腫瘤周邊持續染色和中央放射透光區。
預防措施
許多患者認為,對無症狀或症狀輕微的肝血管瘤不需作任何治療,只需要作觀察隨診就可以了。少數肝血管瘤確實比較穩定,只要定期觀察是可以的,但大部分會保持增大狀態,尤其是年齡在30歲以上年齡段患者增大狀態更是明顯應及時治療。同時,觀察期患者如有肝血管瘤逐步增大。或自感上腹不適、厭食、噁心、長期發熱、冷戰、盜汗等症狀的患者最好及時治療以免病情惡化。建議你最好儘快送來詳細的檢驗報告,由專科大夫給你提供更為專業的指導。發現肝血管瘤一定不要緊張恐懼,要保持心態平和、情緒穩定。應禁酒、禁忌辛辣刺激性食物,忌油膩過重,避免過度勞累和劇烈運動,尤其避免肝區受外力碰撞。最重要的是定期複查。肝血管瘤為良性病變,肝血管瘤雖有先天性因素,但其增長卻是後天因素促成的。所以預防就是要儘量避免引起瘤體增長的因素。如正確對待各種事情,解除憂慮、緊張情緒,避免情志內傷。
肝血管瘤的飲食上也有很多需要注意,具體如下:肝血管瘤病人要:忌煙、酒;忌暴飲暴食、油膩食物,忌鹽醃、煙燻、火烤和油炸的食物,特別是烤糊焦化了食物;忌蔥、蒜、花椒、辣椒、桂皮等辛辣刺激性食物;忌霉變、醃醋食物,如霉花生、霉黃豆、鹹魚、醃菜等;忌多骨剌、粗糙堅硬、粘滯不易消化及含粗纖維食物;忌味重、過酸、過甜、過鹹、過冷食物。肝血管瘤的飲食有這些禁忌,光知道了不行,還要實行,而且要堅持,否則也會影響治療效果的。
總之,肝血管瘤患者平時應多吃新鮮蔬菜,不要喝酒,平時注意鍛鍊身體,如見腹內有積塊、身體消瘦、倦怠乏力等症狀應早期檢查,及時治療。
鑑別診斷
臨床上肝血管肉瘤易與肝瀰漫性毛細血管瘤相混淆,也很難與肝母細胞瘤相鑑別,在成年人肝血管肉瘤須與未分化肝細胞癌鑑別,前者如前述病理部分,瘤細胞質呈嗜酸性,後者呈嗜鹼性,而且異質明顯。多處取材可見癌細胞帶有肝細胞性狀,可資鑑別。
治療方案
局限性結節不伴有肝硬化者,爭取早期發現,早期手術切除。不能切除的腫瘤,可採用化療藥物氟尿嘧啶、長春新鹼、環磷醯胺、多柔比星(阿黴素)、表柔比星(表阿黴素)和(或)放療,可延長病人生存期。
併發症
本病約25%合併肝硬化。腫瘤破裂可致血腹。因腫瘤記憶體在動靜脈分流可引起心力衰竭。血小板在腫瘤內大量消耗,可引起彌散性血管內凝血。
預後及預防
預後:該腫瘤惡性度高,病程發展快,腫瘤切除機會少,總的預後差。未治療的病人,大多數於6~12 個月內死亡,病人一般死於肝功能衰竭或腹腔內出血。
流行病學
肝血管肉瘤是一種間質性腫瘤,惡性程度很高。全球每年約有200 例報導。中國多為個案報導,王玉梅(1985)、蘇恢四(1987)各報導1 例,常維玲(2000)報導2 例。王萬忠(1996)報導了3 例肝原發性血管肉瘤,男性2 例,女性1 例,平均年齡32.7 歲,占同期肝臟惡性腫瘤檢出率的0.69%(3/436)。本病多發生於男性,男女之比為3~5.51∶1。發病高峰年齡在60~70 歲,少數發生在兒童(多在3~5 個月嬰兒)。
